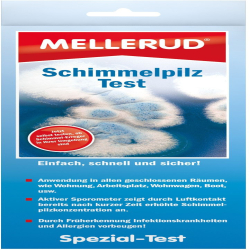
MELLERUD CHEMIE GMBH MELLERUD Schimmelpilz Test, Einfach, schnell und sicher, 1 Test-Set 2001009205

Es wurden 40 Produkte zu dem Suchbegriff Schimmelpilzallergie in 13 Shops gefunden:
-

Schimmelpilz Schnelltester 1 stk
Anbieter: Apolux.de Preis: 34,30 €Schimmelpilz Schnelltester 1 stk
-

Schimmelpilz Schnelltester
Anbieter: Juvalis.de Preis: 34,31 € (+3,99 €)Schimmelpilz Schnelltester können in Ihrer Versandapotheke www.juvalis.de erworben werden.
-

Springer Berlin Heidelberg Schimmelpilze
Anbieter: Link.springer.com Preis: 79,99 €Schimmelpilze – nützlich und schädlich zugleich Dieses Buch gibt einen umfassenden Überblick über die guten und schlechten Seiten der Schimmelpilze. Nach einer Definition und Einführung in das Thema „Schimmelpilze" erörtern die Autoren deren Biologie, Physiologie und Genetik. Weiterhin werden der Einsatz von Schimmelpilzen in der Biotechnologie sowie zur Herstellung von Lebensmitteln und bei der biologischen Schädlingsbekämpfung betrachtet. Im Kapitel Schadwirkung und Bekämpfung geht es um die negativen Auswirkungen von Schimmel als Krankheitserreger bei Pflanzen, Tieren und Menschen sowie um die Zerstörungskraft von Schimmelpilzen auf verschiedenen Materialien. Dieses Sachbuch wendet sich an Studierende der Lebenswissenschaften sowie an fachferne Leser, die berufsbedingt mit der Wirkung von Schimmelpilzen befasst sind. Darüber hinaus sollen auch interessierte Laien durch dieses Buch angesprochen werden. Ein umfassender Überblick zu allen Aspekten von Schimmelpilzen
-

Müller Rudolf Praxis-Handbuch Schimmelpilzschäden
Anbieter: Hugendubel.de Preis: 65,00 €*Praxis-Handbuch Schimmelpilzschäden * - Diagnose und Sanierung. 2. aktualisierte und erweiterte Auflage / 65€ / Buch
-

Professionelle Crimpzange, Werkzeugsatz für hydraulische Pressen, V Schimmelpilze
Anbieter: Kaufland.de Preis: 147,00 €BeschreibungSind Sie noch auf der Suche nach professionellen Crimpzangen, die effizient und arbeitssparend sind? Schauen Sie sich unsere Produkte an, mit denen Sie die meisten Rohre problemlos verpressen können. Hochharte Materialien und exquisite Prozesse sorgen für Robustheit und Langlebigkeit. Es bietet auch Formen in verschiedenen Spezifikationen, um Ihre verschiedenen Crimp-Bedürfnisse zu erfüllen, die zweifellos ein guter Helfer für Ihre Arbeit ist. Wesentliche MerkmaleLanglebig: Der Zylinder aus hochwertigem Cr40-Stahl, der Zangenkopf aus Aluminium und die Formen aus 42Crmo mit Oxidations-, Härte- und Schwärzungsprozessen sind abrieb- und rostbeständig und bieten eine hervorragende Leistung für den langfristigen Gebrauch. Praktisch und kraftvoll: Dieses Produkt verfügt über ein hydraulisches Design, mit einer maximalen Crimpkraft von 10T, die Ihnen helfen kann, das Crimpen mit weniger Aufwand abzuschließen. Die V12, V15, V18, V22, V28 Formen können Ihre verschiedenen Nutzungsanforderungen erfüllen. Durchdachtes Design: Der Zangenkopf ist mit einer kleinen Schraube befestigt, und Sie können ihn je nach Bedarf um 360° drehen. Bei der Verwendung greift die Zange fest und quetscht den Gegenstand, ohne abzufallen. Leicht zu transportieren und zu verstauen: Der Werkzeugkasten mit integriertem Griff und sein kompaktes und leichtes (11,02 lbs) Design machen es einfach, diese Werkzeuge zu verstauen, ohne dass sie verloren gehen oder beschädigt werden, und sie können bequem zu jeder Baustelle getragen werden. Hervorragende Dichtungsleistung: Der Dichtungsring und der Anti-Leck-Kolben können den Zylinder gut abdichten und das Auftreten von Ölleckagen reduzieren. Einfache Handhabung: Das ergonomische Design nutzt das Prinzip der Hebelwirkung und eine hohe Rückstellfeder für eine mühelose Handhabung. Einfache Wartung: Er hat eine glatte Oberfläche und eine einfache Struktur, so dass Sie die Oberfläche mit einem feuchten Lappen von Flecken befreien können. Ideales Geschenk: Dank seiner Praktikabilität und Kosteneffizienz können Sie es als Weihnachts-, Thanksgiving- oder Einweihungsgeschenk an Ihre Arbeiter- oder Hobby-Heimwerker-Freunde verschenken. Kundenbetreuung: Wir sind bestrebt, qualitativ hochwertige Produkte und Dienstleistungen anzubieten. Wir werden antworten und das Problem für Sie so schnell wie möglich lösen. EinzelheitenBequemer Handgriff: Der ergonomische, isolierte Griff mit wellenförmigem Design liegt bequem in der Hand, ohne abzurutschen, und verringert die Ermüdung der Hände. Druckentlastungsschalter: Der Druckentlastungsschalter erleichtert Ihnen das sichere und zuverlässige Ablassen des Drucks nach dem Crimpen. Arretierstift: Er kann zum Auswechseln der Form leicht entfernt werden. Außerdem verhindert er, dass die geladenen Formen herunterfallen. AnwendungEs kann zum Verpressen von Kupferrohren verwendet werden. Es ist weit verbreitet in den Bereichen der elektrischen Energie, Kommunikation, Transport, Erdöl, chemische Industrie, Bergbau, Metallurgie, Schiffbau, und so weiter. Wie zu verwenden1. Prüfen Sie, ob die Spezifikationen der Form und des Rohrs übereinstimmen.2. Wählen Sie die passende Form aus.3. Laden Sie die Form.4. Drehen Sie den Ölrücklaufschalter im Uhrzeigersinn und kurbeln Sie wiederholt an der Kurbel.5. Wenn sich die obere und die untere Form an einer Stelle berühren, ist der Crimpvorgang abgeschlossen.6. Lösen Sie dann den Ölrücklaufschalter. Technische DatenFarbe: OrangeGrifftyp: ErgonomischModell: CW-1632Hub: 20mm/0.79inMaterial: Aluminium, Cr40 Stahl, 42CrmoVerfahren: Oxidiert, abgeschreckt, und geschwärzt BehandlungMaximale Crimpkraft: 10T/100KNV-Formen Spezifikationen: V12, V15, V18, V22, V28Lochdurchmesser: 12mm/0.47in Zangenkopf Max. Breite: 58mm/2.28inLänge des Zangenkopfes: 13cm/5.12 inGeschlossene Grifföffnung: 12cm/4.72inGrifflänge: 23cm/9.06in, 27cm/10.63inGesamtlänge: 41cm/16.14inPaketgröße: 45*22*11cm/17.72*8.66*4.33inBruttogewicht: 5.5kg/12.13 lbsNettogewicht: 5kg/11.02 lbs Inklusive Paket1* Crimpzange1* Schmetterlingsform5* V-Formen1* Werkzeugkasten1* Englische Anleitung Hinweise1. Bitte überprüfen Sie die Produktspezifikation vor dem Kauf.2. Bitte lesen Sie die englische Bedienungsanleitung und das Produktetikett vor dem Gebrauch sorgfältig durch und achten Sie besonders auf die darin enthaltenen Sicherheitshinweise.3. Es ist strengstens verboten, das Werkzeug ohne Form zu verwenden. Bitte verwenden Sie die richtige Formgröße und stecken Sie Ihre Finger nicht in die Form während des Gebrauchs.4. Bitte quetschen Sie keine stromführenden Kabel oder Drähte.5.
-

Vde Verlag GmbH Schimmelpilzbildungen In Gebäuden
Anbieter: Hugendubel.de Preis: 42,00 €*Schimmelpilzbildungen in Gebäuden * - Bautechnische Maßnahmen zur Vorbeugung Beseitigung und Instandsetzung. 5. überarbeitete und erweiterte Auflage / 42€ / Taschenbuch
-
MELLERUD CHEMIE GMBH MELLERUD Schimmelpilz Test, Einfach, schnell und sicher, 1 Test-Set 2001009205
Anbieter: Hygi.de Preis: 22,85 € (+5,89 €)Anwendungsbereich einsetzbar in allen geschlossenen Räumen Wohnung, Keller, Wohnwagen, Gartenhaus, Boot, Arbeitsplatz Anwendung Das Sporometer aus der Verpackung nehmen und waagerecht am Testort positionieren. Schutzfolie entfernen. Nach 30 Minuten die Testbox verschließen und in den Karton legen. 5 Tage lagern um das Wachstum der Mikroorganismen zu ermöglichen. Nun können Sie die gewachsenen Kolonien zählen und anhand der Richtwerttabelle auswerten. Hinweise Schimmelpilze können bevorzugt bei hoher Luftbelastung Krankheiten bzw. schwere Infektionskrankheiten hervorrufen! Der Test wird in eine
-

AUXYNHAIROL Schimmelpilz Schnelltester 1 St Test
Anbieter: Shop-apotheke.com Preis: 42,99 €Schimmelpilz Schnelltester AeroSpor Mikrobiologischer Schnelltest zur Bestimmung von Schimmelpilzen in der Raumluft. Inhalt: 3 x AeroSpor-Testplatten 2 x PE-Einweghandschuhe 1 x Gebrauchsanweisung Allgemeine Angaben zum Testprinzip Schimmelpilze sind Mikroorganismen, die Sporen bilden, die auf Grund ihrer minimalen Größe in der Luft schweben und für den Menschen mit bloßem Auge nicht sichtbar sind. Bei dem hier angewandten Testverfahren, fallen die Pilzsporen aus der Luft, auf eine feuchte mit Nährstoff versehene Testfläche, auf der sich die Mikroorganismen vermehren und nach der Inkubationszeit (96 Stunden) eine sichtbare mehr oder weniger runde oder gelappte Kolonie bilden. Je mehr Schimmelpilzsporen auf die Testfläche fallen, um so mehr Kolonien entstehen, die man dann leicht zählen kann. Das Ziel des Testes ist es also die Bestimmung der Anzahl lebender Schimmelpilzsporen in der Raumluft, die in einer bestimmten Zeit (30 Minuten Testzeit) zufällig auf die Testfläche fallen und dort als Kolonie sichtbar werden. Um icher zustellen, dass die Ursache der Schimmelpilzsporen sich innerhalb des Raumes befindet, ist es zwingend erforderlich auch den Schimmelpilzsporengehalt der Außenluft zu testen. Damit ein zuverlässiges Ergebnis erzielt wird, sollte der Test in einem geschlossenen Raum von nur einer Person durchgeführt werden. Unnötige Luftbewegungen sind zu vermeiden. Der Vergleich der ermittelten Koloniezahl mit einer Richtwerttabelle liefert erste Hinweise, ob eine Schimmelpilzbelastung der Luft vorliegt. Die begrenzte Testdauer (30 Minuten) und die anschließende Inkubation (96 Stunden) hei Raumtemperatur führt dazu, dass sehr langsam wachsende und/oder an hohe Temperaturen angepasste Pilze als Kolonien nicht sichtbar werden. Obwohl mit diesem preiswerten Test eine exakte Bestimmung der tatsächlichen Keimzahl nicht möglich ist, erhält der Verbraucher doch erste Informationen über die Qualität der Luft. Bestimmung der Schimmelpilzbelastung Auf den AeroSpor-Testflächen wachsen nur Schimmelpilze! Schimmelpilzkolonien sind meist filzig weiß. Vom Zentrum zum Rand hin sind deutlich Fasern (Hyphen) zu sehen, die den Kolonialrand wimpernförmig darstellen. Mit unehmen- der Inkubationsdauer färbt sich das Zentrum der Pilzkolonie durch das entstehen von Sporen meist grün, schwarz oder manchmal braun-rot oder gelb. Nur selten entstehen schleimig-glänzende Kolonieoberflächen. Bei einigen sehr schnell wachsenden Pilzen entsteht ein grauweißes, watteartiges Geflecht mit winzigen schwarzen Sporen. Dieses kann große Teile der Testfläche bedecken. Maßnahmen zur Bekämpfung von Schimmelpilzen Beseitigen Sie Feuchtigkeit in Keller- und Wohnräumen durch Bausanierung Beseitigen Sie sichtbare Schimmelflecken durch Trockenlegung und chemischer Schimmelentfernung Beheizen und belüften Sie die betroffenen Räume und ergreifen Sie Hygienemaßnahmen z.B. reinigen Sie mit Desinfektionsmittel Entfernen Sie überlagerte Nahrungsmittel/Reste Reinigen Sie Stellen, an denen...
-

Auxynhairol-Vertrieb SCHIMMELPILZ Schnelltester 1 St 03800468
Anbieter: Ipill.de Preis: 44,26 € (+3,95 €)SCHIMMELPILZ Schnelltester
-

Auxynhairol-Vertrieb Schimmelpilz Schnelltester 03800468
Anbieter: Apodiscounter.de Preis: 36,96 €Schimmelpilz Schnelltester können in Ihrer Versandapotheke apodiscounter erworben werden.
-

Auxynhairol-Vertrieb Sylvia Janeikis e.K. SCHIMMELPILZ Schnelltester 1 St.
Anbieter: Fliegende-pillen.de Preis: 39,24 €SCHIMMELPILZ Schnelltester 1 St. von Auxynhairol-Vertrieb Sylvia Janeikis e.K. (PZN 03800468) günstig kaufen bei Fliegende-Pillen.de - seit über 10 Jahren Ihre Versandapotheke. Günstig, diskret, sicher.
-

Springer Berlin Heidelberg Krankheiten durch Schimmelpilze bei Mensch und Tier
Anbieter: Link.springer.com Preis: 79,99 €Das Thema "Krankheiten durch Schimmelpilze bei Mensch und Tier" wirft Fragen auf, deren Beantwortung nur gelingt, wenn alle Fachrichtun gen der Medizin, Tiermedizin und Biologie die Probleme gemeinsam bearbeiten. Dieser Erkenntnis folgend, vereinte die 3. wissenschaftliche Tagung der "Deutschsprachigen Mykologischen Gesellschaft" am 6. und 7. Juli 1963 in Wiesbaden namhafte Vertreter des In- und Auslandes, um im Diskussionsgesprach zu klaren, welche Bedeutung bestimmten Pilzen zu kommt, die als "Saprophyten" von toter organischer Substanz leben und in der Umgebung von Mensch und Tier weit verbreitet sind. Da diese schimmelartig aussehenden Pilze jedoch nicht nur als "Anflug keime" oder als "Kontaminanten" bei mikroskopischer oder kultureller mykologischer Untersuchung aufgefunden werden kannen, sonder- primar oder sekundar - auch in der Pathogenese von Dermatomykosen und insbesondere von inneren Mykosen eine Rolle spielen, ist es dringend geboten, alle wesentlichen Tatsachen leicht zuganglich zu machen. Diesem Zweck dient die vorliegende Zusammenstellung, die sich an die Vortrage und Diskussionsbemerkungen der Wiesbadener Tagung anlehnt und in ubersichtlich geordneter Form Grundbegriffe, experimentell gewonnene Ergebnisse, Klinik, Diagnostik und Therapie der "Schimmel pilzerkrankungen" aus der Sicht des Arztes, des Tierarztes und des Biologen behandelt. Mage die kleine Schrift es dem Leser erleichtern, sich in einem Gebiet zu orientieren und zurechtzufinden, dessen Grenzen sich mehr und mehr abzuzeichnen beginnen! So richtig es ist, gerade auf dem Gebiet der "Schimmelpilze" vorsichtig abwagend zu urteilen, so sehr muB anderer seits verlangt werden, daB sich ein solches Urteil nicht auf Dogmen und Annahmen, sondern auf exakte Befunde und beweisbare Tatsachenstutzt.
-

Schleich Baby Sammelpilze (70809)
Anbieter: Galaxus.de Preis: 5,75 €Schleich Baby Sammelpilze (70809)
-

Goldegg Schimmel Arsch Und Zwirn. Anekdoten Und Wissenswertes Über Eine Allgegenwärtige Plage. Wie Gefährlich Sind Schimmelpilze Und Sporen? Was Verursacht Schimmelbefall? Wie Kann Ich Schimmel Entfernen?
Anbieter: Hugendubel.de Preis: 22,00 € (+3,95 €)*Schimmel Arsch und Zwirn. Anekdoten und Wissenswertes über eine allgegenwärtige Plage. Wie gefährlich sind Schimmelpilze und Sporen? Was verursacht Schimmelbefall? Wie kann ich Schimmel entfernen? * / 22€ / Taschenbuch
-

Gistuch 6pcs Acrylvorlage DIY Handgefertigte kurze Brieftaschen -Leder -Muster -Schimmelpilzwerkzeuge DIY
Anbieter: Kaufland.de Preis: 25,99 €Besonderheit:1. Sie können dieses Modell verwenden, um eine kurze Brieftasche herzustellen, was ein einzigartiges Handwerk für sich selbst ist 2. Acrylvorlage ist transparent und klar, einfach zu sparen und kann für eine lange Zeit verwendet werden 3. Eine Schicht Kraftpapier auf Schimmel, um Kollision und Kratzer während des Transports zu verhindern V. 5. Ledervorlage besteht aus hochwertigem Acrylmaterial, das für eine lange Lebensdauer langlebig ist Spezifikation:Elementtyp: Acrylvorlage Material: Acryl Funktion: Die Vorlage kann verwendet werden, um eine kurze Brieftasche zu erstellen Fertiger Stil: Kurzer Brieftasche Größe der fertigen Produktgröße: ca. 12 x 10 x 2 cm / 4,7 x 3,9 x 0,8 Zoll Material Beschreibung: ca. 2,54 5,08 cm / 1 2in (nur als Referenz) Gebrauchsvorschläge: 1. Hartes Leder wie Gemüseleder wird empfohlen, an der Musterlinie mit einem Abrieb geschnitten oder direkt mit einem Ledermesser geschnitten zu werden. 2. Für ein Leder, das mit speziellem Handwerk verarbeitet wurde, kann der Kortex nicht mit einer AWL gekennzeichnet werden, sodass er mit Silber -Nachfüllstiftstrichen geschnitten werden muss. Größe: ca. 20,5 x 9 cm / 8,1 x 3,5 Zoll 22,5 cm / 8,9in 8,2 x 5,2 cm / 3,2 x 2in 16cm / 6,3in 22,5 x 10 cm / 8,9 x 3,9 Zoll 20,5 x 6,5 cm / 8,1 x 2,6 Zoll Paketliste:6 x Acrylvorlage
-

Schleich CDU 22 Sammelpilze 2024, sortiert (70657)
Anbieter: Galaxus.de Preis: 72,10 €Schleich CDU 22 Sammelpilze 2024, sortiert (70657)
-

Gistuch 2pcs 5,4 mm Silikon Bienenwachs Fundament Blatt Handbuch Pressempfrossser DIY Schimmelpilze Bienenzuchtgeräte
Anbieter: Kaufland.de Preis: 29,99 €Eigenschaften:1. Silikonmaterial: Die Bienenwachsplattenform besteht aus Silikonmaterial, ist weich und langlebig und wird zum Pressen von Bienenstöcken in der Bienenzucht verwendet. 2. Erhabenes Muster: Bienenwachs-Pressplattenform kann auch zum Pressen des Bienenstockmusters anderer Produkte verwendet werden. Das Material ist weich, stark und leicht zu reinigen. 3. Größere Größe: Das Set enthält 2 Stück Blattform, Silikon-Bienenwachs-Pressform eignet sich zum Pressen großer oder mehrerer kleiner Größen. 4. Schön und praktisch: Exquisite Verarbeitung, schönes Aussehen. Das Formwerkzeug aus Bienenwachs ist praktisch, einfach zu bedienen, arbeitssparend und wiederverwendbar. 5. Kompakt und tragbar: Klein, leicht, kann nach Gebrauch zusammengeklappt werden (während des Zusammenklappens und Aufbewahrens können keine schweren Gegenstände gedrückt und platziert werden), einfach zu tragen und aufzubewahren und einfach zu bedienen. Spezifikation:Elementtyp: Bienenwachsblech Form Material: Silikon Bruttogewicht: 593g / 20,9oz Größe des Außendurchmessers: 44,2 x 28cm / 17.4x11.0in Größe der Bienenwachs -Produkte: 41,7x27cm / 16.4x10.6in Spezifikation: 5.4mm / 0,4mm / 0,2in Nachdem der Kunde die Waren erhalten hat (so weit wie möglich während des Falten- und Speichervorgangs, sollte keine schweren Objekte gedrückt und platziert werden) How to Use:Das Silikonblechmodell wird auf eine flache Oberfläche gelegt, und die vom Kunde hergestellte Bienenwachslösung wird in die Form gegossen, die für einen bestimmten Zeitraum gedrückt wird, um in ein Wachsblatt zu verfestigen, und dann ist der Betrieb abgeschlossen. (Hinweis: Nur die Silikonblechform wird geliefert). Paketliste:1 Setzen Sie x Bienenwachs -Presseblatt (2 Teile) Hinweis:1. Es kann gefaltet und gespeichert werden, aber beim Falten können keine schweren Objekte auf die Silikonform gedrückt werden. 2. Für die Lieferung nicht faltbar. 3. Es gibt positive und negative 3 cm -Fehler beim manuellen Schneiden.
-

Schleich Bayala Baby Sammelpilze 2024 sortiert 70657
Anbieter: Kaufland.de Preis: 66,01 €Figurki mini kolekcjonerskie Bayala (22szt) Mit großen Kulleraugen schaut der kleine Babypilz in die Welt. Das bunte Pilzköpfchen ist mit Glitzer bestäubt. Das sieht zu niedlich aus! Besonders wohl fühlt sich der Babypilz in der Nähe seiner vielen Geschwister. Die süßen Kleinen sind mit ihren leuchtenden Farben schon von Weitem zu sehen. Ein Sammelposter hat der Babypilz auch dabei. Schleich Display Baby Toadstools 2024 (22 stuks)
-

BONDI Baby Mädchen Leggings "Pilzallover" 86686 | Grün Größe: 74 86686-170
Anbieter: Kaufland.de Preis: 14,95 €- Deutscher Hersteller: BONDI Kidswear - Lieferumfang: Leggings - einfaches An- und Ausziehen durch den breiten Gummibund - trachtiges Pilzallover - elastisches, weiches Baumwollmaterial Diese Leggings wird Ihr kleines Mädchen lieben. Die elastische Hose ist aus weichem Baumwollmaterial gefertigt und mit unzähligen, kleinen Pilzen auf grünem Hintergrund designt. Das kleine Lebkuchenherz an der Hüfte rundet das Gesamtpaket perfekt ab.
-

BONDI Baby Mädchen Leggings "Pilzallover" 86686 | Grün Größe: 68 86686-170
Anbieter: Kaufland.de Preis: 14,95 €- Deutscher Hersteller: BONDI Kidswear - Lieferumfang: Leggings - einfaches An- und Ausziehen durch den breiten Gummibund - trachtiges Pilzallover - elastisches, weiches Baumwollmaterial Diese Leggings wird Ihr kleines Mädchen lieben. Die elastische Hose ist aus weichem Baumwollmaterial gefertigt und mit unzähligen, kleinen Pilzen auf grünem Hintergrund designt. Das kleine Lebkuchenherz an der Hüfte rundet das Gesamtpaket perfekt ab.
40 Ergebnisse in 0.382 Sekunden
Ähnliche Suchbegriffe
© Copyright 2026 shopping.eu